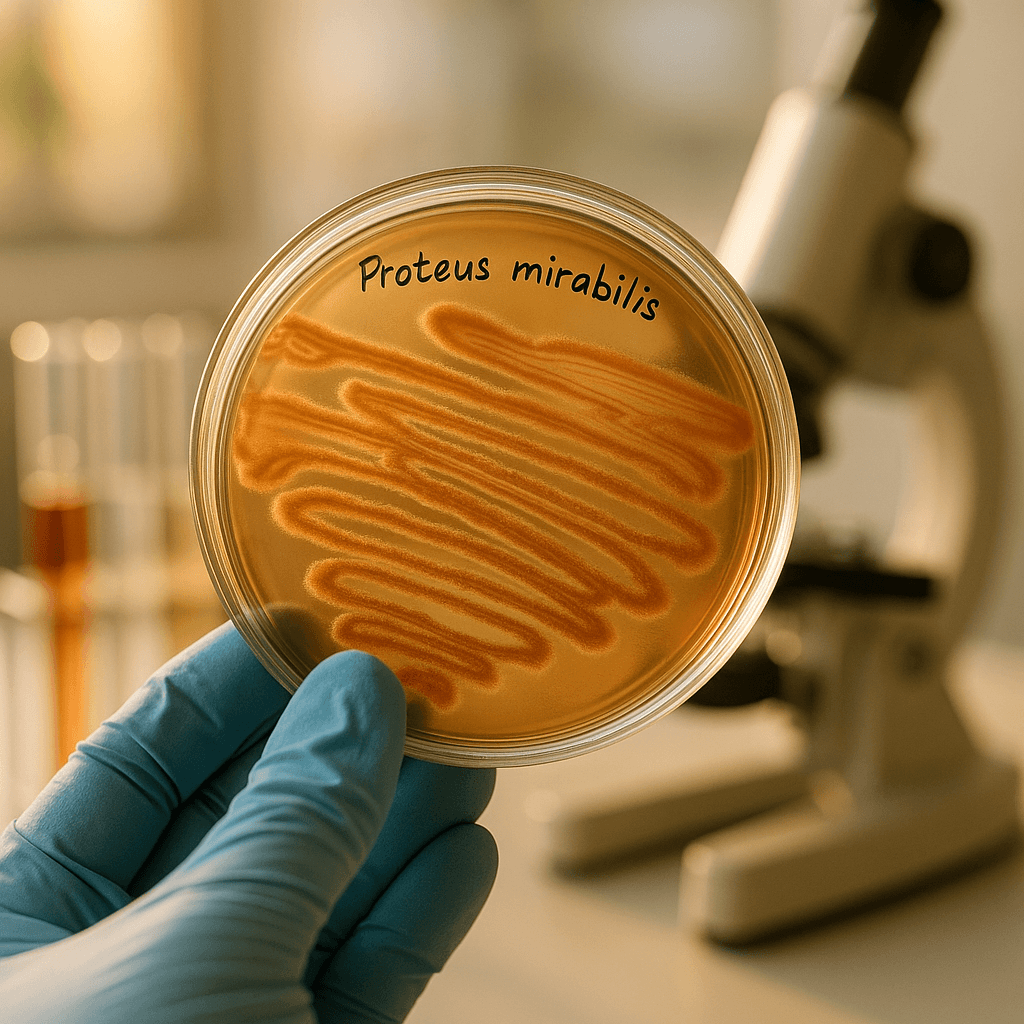

Pas le temps de lire ? En bref : Proteus mirabilis est une bactérie opportuniste présente normalement dans notre flore intestinale, mais qui peut provoquer des infections urinaires lorsqu’elle migre. Cette bactérie produit de l’uréase, augmentant le pH de l’urine et favorisant la formation de cristaux et de calculs rénaux. Les symptômes incluent des brûlures lors de la miction et des douleurs lombaires. Pour prévenir les complications, une prise en charge appropriée et rapide est cruciale.
Proteus mirabilis : Comprendre cette bactérie et ses effets sur les infections urinaires
Qu’est-ce que Proteus mirabilis ?
Proteus mirabilis est une bactérie de la famille des Gram-négatifs que l’on retrouve naturellement dans notre flore intestinale. Tant qu’elle reste à sa place habituelle, elle ne pose pas de problème. Cependant, cette bactérie peut causer des soucis lorsqu’elle migre, notamment vers les voies urinaires. Pourquoi cela ? Elle agit en tant que pathogène opportuniste, cherchant à coloniser de nouvelles zones lorsque les défenses de l’organisme sont diminuées, par exemple lors de l’utilisation de sondes urinaires. Ce changement de lieu peut induire diverses infections.
Proteus mirabilis se distingue par sa production de l’enzyme uréase. Cette enzyme transforme l’urée présente dans l’urine en ammoniaque, entraînant une augmentation du pH. Quelles sont les conséquences ? Un environnement propice à la formation de cristaux pouvant évoluer en calculs rénaux. Cependant, si l’on trouve cette bactérie dans l’urine, cela ne signifie pas automatiquement qu’il y a infection. Elle peut être présente sans causer de symptômes, et seul un examen médical permet de définir la nécessité d’un traitement.
Pourquoi cette bactérie est-elle si particulière ?
L’action de l’uréase est essentielle dans la manière dont Proteus mirabilis provoque des infections urinaires. En transformant l’urée en ammoniaque, le pH de l’urine augmente, ce qui altère l’environnement naturel de la vessie. Le résultat ? Un milieu favorable à la précipitation de cristaux, souvent composés de struvite. Ces cristaux peuvent rapidement former des calculs rénaux. Ces calculs ne sont pas anodins : ils risquent de bloquer les voies urinaires, entraînant des douleurs et des infections plus intensifiées.
Quels symptômes peut provoquer Proteus mirabilis ?
Dans le contexte d’une infection urinaire causée par Proteus mirabilis, les symptômes varient selon la partie affectée des voies urinaires. Les signes typiques d’une infection urinaire incluent des brûlures lors de la miction, une envie fréquente d’uriner, souvent accompagnée d’urines troubles ou malodorantes. Si l’infection touche les reins, des douleurs dans le bas du dos, de la fièvre, voire des frissons peuvent survenir. Il est possible, bien sûr, de n’avoir aucun symptôme apparent, compliquant ainsi le diagnostic sans analyse spécifique.
Symptômes urinaires les plus fréquents
Pour reconnaître une infection urinaire due à Proteus mirabilis, on peut s’attendre à :
- Des brûlures lors de la miction.
- Un besoin fréquent d’uriner.
- Des urines troubles ou à odeur désagréable.
- Des douleurs pelviennes.
Signes d’une atteinte plus sévère
Lorsque l’infection s’aggrave, elle se manifeste par :
- Une fièvre persistante.
- Des douleurs dans la région lombaire.
- Des frissons.
- Une dégradation de l’état général.
Il est impératif de consulter un professionnel de santé si ces symptômes apparaissent.
Comment attrape-t-on une infection à Proteus mirabilis ?
L’origine intestinale de Proteus mirabilis lui permet de migrer vers les voies urinaires, surtout en cas d’hygiène insuffisante ou lors d’interventions médicales spécifiques. Les signes urinaires sont susceptibles de s’intensifier en présence de divers facteurs de risque.
Facteurs de risque principaux
Certaines conditions favorisent l’infection par Proteus mirabilis :
- Utilisation de sonde urinaire prolongée.
- Séjour hospitalier étendu.
- Présence de calculs urinaires déjà existants.
- Affaiblissement du système immunitaire.
Ces situations requièrent une vigilance accrue pour empêcher une infection urinaire.
Pourquoi Proteus mirabilis peut-elle entraîner des complications ?
Le danger principal de Proteus mirabilis réside moins dans les infections urinaires de base que dans sa propension à engendrer des complications sévères. Parmi celles-ci, la formation de calculs rénaux à base de struvite est prédominante. Ces calculs favorisent les infections récidivantes et accroissent le risque de propagation de l’infection à d’autres parties de l’appareil urinaire, voire de provoquer une pyélonéphrite, une infection rénale sérieuse.
Calculs rénaux liés à Proteus : Mécanisme et conséquences
Les calculs de struvite liés à la présence de Proteus mirabilis peuvent devenir problématiques rapidement. Non seulement ces calculs obstruent le passage de l’urine, augmentant ainsi la pression sur les reins, mais ils peuvent aussi devenir des récidivistes, relançant ainsi le cycle d’infection et de douleur.
Comment se fait le diagnostic ?
Pour identifier Proteus mirabilis, un Examen Cytobactériologique des Urines (ECBU) s’avère nécessaire. Ce test permet d’identifier la bactérie responsable et de réaliser un antibiogramme, qui indique les antibiotiques les plus efficaces contre elle. Lire une analyse d’urine implique de comprendre les seuils bactériens, différenciateurs entre une simple colonisation et une infection nécessitant un traitement.
Interpréter un résultat mentionnant Proteus mirabilis
La détection de cette bactérie dans une analyse d’urine doit être minutieusement interprétée. Comprendre le seuil bactérien est crucial pour déterminer s’il s’agit d’une colonisation asymptomatique ou d’une infection nécessitant intervention. L’évaluation doit prendre en compte aussi bien la concentration bactérienne que les symptômes cliniques observés chez le patient.
Comparaison avec les autres bactéries urinaires
Dans le domaine des infections urinaires, d’autres bactéries peuvent également être en cause. Voici un aperçu comparatif :
| Bactérie | Fréquence | Particularité | Complication principale |
|---|---|---|---|
| E. coli | Très fréquente | Origine digestive | Infection simple |
| Proteus mirabilis | Moins fréquente | Uréase positive | Calculs rénaux |
| Klebsiella | Variable | Résistance possible | Infection compliquée |
Évolution et prise en charge d’une infection
Traiter une infection à Proteus mirabilis demande un traitement antibiotique adapté, basé sur les résultats de l’antibiogramme. La prévention des complications, telles que la formation de calculs rénaux, est cruciale. En cas de récidive, un réexamen exhaustif du patient est préconisé pour ajuster le traitement.
FAQ :
- Qu’est-ce que Proteus mirabilis ? → Une bactérie connue pour favoriser les infections urinaires, entre autres via la formation de calculs.
- Est-ce grave ? → Dépend du contexte : souvent sans gravité, mais risque de complications avec calculs ou infections rénales.
- Comment savoir si on est infecté ? → Via une analyse d’urine (ECBU).
- Peut-on avoir Proteus sans symptôme ? → Oui, il s’agit alors d’une colonisation.
- Pourquoi cette bactérie donne des calculs ? → L’uréase modifie le pH urinaire, facilitant la formation de cristaux.
En conclusion, bien comprendre Proteus mirabilis est fondamental pour prévenir et gérer efficacement les infections urinaires. Soyez attentif aux symptômes et sollicitez un professionnel de santé en cas de doute. Ces informations ne remplacent toutefois pas une consultation médicale. Pour toute suspicion ou symptôme persistant, rendez-vous chez un professionnel de la santé.